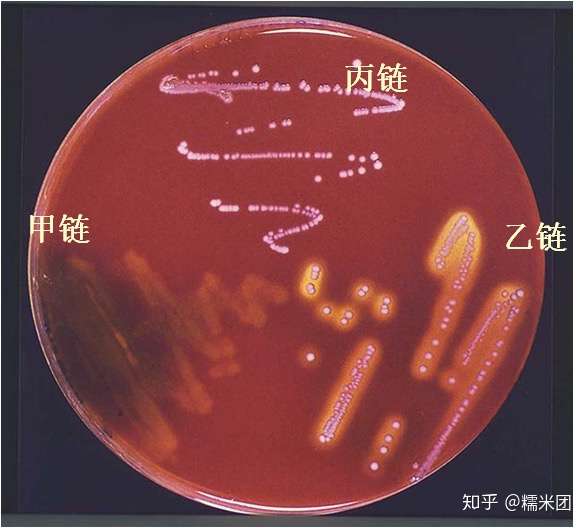
链球菌为什么会导致局部感染扩散

血链球菌

流产妇感染b族β溶血链球菌1例
图片尺寸391x391
链球菌菌落对血ag具有溶血性
图片尺寸1200x800
链球菌为什么会导致局部感染扩散
图片尺寸588x528
下图中最符合乙型溶血性链球菌在血平板生长的菌落特点的是
图片尺寸387x383
微生物检验肺炎链球菌
图片尺寸1080x1080
乙型溶血链球菌鉴定求助
图片尺寸3264x2448
溶血性链球菌感染
图片尺寸800x600
乙型溶血链球菌鉴定求助
图片尺寸3264x2448
转载细菌大盘点大肠埃希氏菌血链球菌李斯特菌
图片尺寸1134x483
下图中最符合乙型溶血性链球菌在血平板生长的菌落特点的是
图片尺寸484x449
血液中的链球菌
图片尺寸1200x800
下图中最符合乙型溶血性链球菌在血平板生长的菌落特点的是
图片尺寸564x424
下图中最符合乙型溶血性链球菌在血平板生长的菌落特点的是
图片尺寸586x485
链球菌菌落在血液上具有溶血性
图片尺寸1200x800
接种血平板 革兰染色出来是这样的 请问是球菌还是链球菌还是杆菌阿?
图片尺寸1024x1024
第三十八讲肺炎链球菌全方位的博弈
图片尺寸743x617
溶血性链球菌的检验
图片尺寸404x271
溶血性链球菌感染
图片尺寸800x598
溶血性链球菌感染
图片尺寸611x450
camp实验(初步鉴定b群链球菌的实验)_摘编百科
图片尺寸586x679